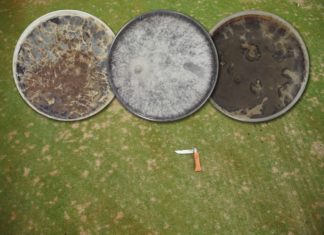
Dollar Spot : Sclerotinia Homoeocarpa n’est plus : place à Clarireedia Dollar spot header
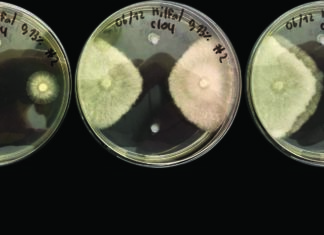
Comprendre la résistance aux fongicides

NMND : niveau minimum pour une nutrition durable des greens de golf
Cet article est téléchargeable au format *.pdf en cliquant sur le lien suivant.
Introduction
Sur les parcours de golf, il est possible d’obtenir des greens de qualité malgré des teneurs en nutriments en-dessous des recommandations conventionnelles. C’est une des conclusions paradoxales...
Dollar Spot : Sclerotinia Homoeocarpa n’est plus : place à Clarireedia
Préambule
Cet article est basé sur la publication parue sur le journal "Fungal Biology" en Août 2018 issue des travaux de l’USDA, l'université de Rutgers, de Caroline du Nord et de l’Ohio. Elle est consultable gratuitement en anglais en...
Pyriculariose du gazon : point sur la maladie et solutions à mettre en oeuvre
Introduction
Eté 2018, Bordeaux, Toulouse, Lyon, Saint-Etienne, Nantes, Angers, Lorient, Reims, Troyes, Monaco, des villes dont le point commun est le nom d’un champignon pathogène ravageant leur pelouse de stade de Ligue 1 ou 2. Son nom : Pyricularia...
Quelle variété d’agrostide pour green lors de l’aération de printemps?
Introduction
Alors que les plannings de compétitions sont toujours plus remplis, il devient difficile pour le greenkeeper de réaliser l'aération de printemps dans les conditions optimales de températures. Il n'est pas rare désormais de voir des aérations début Mars pour...
Le point sur les agrostides pour greens de golf : synthèse des essais mondiaux
Introduction
Les agrostides possèdent la particularité unique de former des pelouses extrêmement denses, uniformes et esthétiques sous des tontes rases (15 mm) à très rases (3mm). Par conséquent, elles sont souvent utilisées dans des zones à forte maintenance comme les...
Comprendre la résistance aux fongicides
Eléments fondamentaux et conséquences pratiques sur la gestion des maladies du gazon – R. Latin, Ph.D
Article original :
“Understanding Fungicide Resistance, R. Latin, 2017, Green Section Record. Vol. 55(13)1:7”
Traduit par R. GIRAUD avec la permission de l’USGA Green Section Record.
Cet...
A propos
Pourquoi la clinique du gazon ?
Après 11 années d'expérience dans la recherche et le développement de produits pour l'entretien des gazons, j'ai décidé de créer ce site web dont le but est de fournir aux intendants des informations précises...